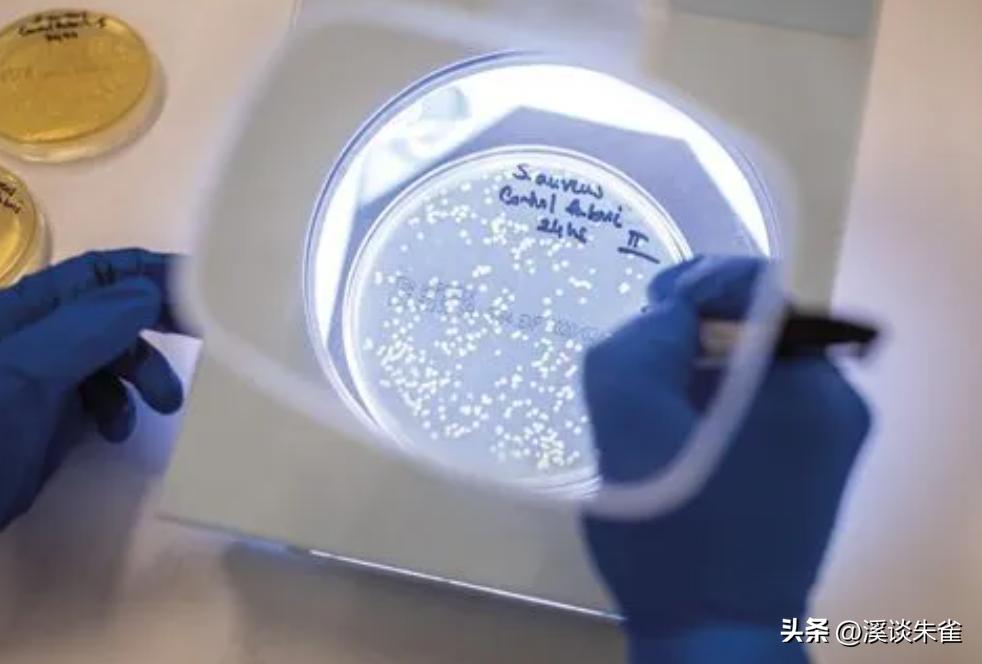
牛流行性腹泻疫苗免疫结果,肠道病毒疫苗终身受益吗

文/编辑丨溪谈朱雀
在阅读之前,麻烦您点一下“关注”,方便您进行讨论和分享、增加阅读体验,感谢您的支持。

牛肠道病毒(BEV)于1957年首次报道,目前在美国、加拿大、英国、德国、波兰、巴基斯坦和中国等全球主要养牛国家和地区流行。BEV感染通常表现为亚临床症状,但在某些情况下可引起腹泻和呼吸道疾病。BEV 使用多种动物作为宿主,包括牛、驼鹿、绵羊、负鼠和海豚。
在某些情况下,人类血液样本也检测出该病毒呈阳性。
根据最新病毒分类,牛肠道病毒分为EV-E和EV-F两类,其中EV-E分为四个亚型(EV-E1-E4),EV-F分为六个亚型(EV-F1-F6)。BEV是小核糖核酸病毒科肠道病毒属的成员。

病毒颗粒呈球形、二十面体、无包膜,直径为 25-30 nm。病毒基因组为不分段的单链正链RNA,全长约7.5 kb。
它可以直接将多蛋白翻译为 mRNA,并经过一系列降解步骤,产生四种结构蛋蛋白(VP1-VP4)和七种非结构蛋白(2A pro、2B、2C、3A、3B、3C pro和3D),其中病毒蛋白酶3Cpro可识别并切割暴露且灵活的结构域内的特征氨基酸序列 (ALPQG)。
BEV通常被认为是无毒力或低毒力,致病性不高,耐酸性环境,可以通过肠道感染动物,使其成为疫苗载体的良好候选者。

尽管在重组和嵌合人类肠道病毒(例如脊髓灰质炎病毒和EV-71病毒)的开发方面取得了实质性进展,但在这方面对BEV的研究相对较少。
于是,研究人员便将口蹄疫病毒(FMDV)O型保守中和表位8E8插入,BEV(BHM26株)的VP1 BC或DE环中。
通过将流感病毒血凝素(HA)表位分别插入BEV(HY12株)的3A或VP1基因中,构建了重组感染性BEV克隆。
这些研究表明,重组BEV的生物学特性与亲本病毒相似,实验感染动物模型可以对外源基因产生免疫反应。然而,这些研究仅探索了一些流行菌株和潜在插入位点,许多其他菌株和其他高效的潜在插入位点仍有待研究。

牛病毒性腹泻病毒(BVDV)是一种单链正链RNA病毒,属于黄病毒科和瘟病毒属,是引起牛病毒性腹泻(BVD)的原因。
BVD 是一种具有多种临床表现的复杂疾病,被认为是全球养牛业的主要威胁之一。BVDV不仅感染牛,还感染绵羊、山羊、猪、鹿等反刍动物,宿主范围广泛。
由于目前BVD尚无特效治疗方法,寻找新的措施来预防其发生和传播就显得尤为重要。BVDV E0 基因在 BVDV 基因组中高度保守,并具有中和表位 [ 19],它可以产生中和抗体来中和BVDV。
因此,研究人员探索了 BVDV E0 作为使用 BEV 进行亚单位疫苗基因工程候选抗原的可能性。

在本研究中,研究人员使用BEV BJ101毒株作为病毒载体,通过在编码非结构蛋白2C和3A的基因之间插入BVDV E0基因来表达外源基因。
研究人员将插入后获救的重组病毒与亲本病毒的复制、感染和生物学特性进行了比较,并评估了E0蛋白的表达及其在体内诱导免疫反应的能力。
根据资料说明,使用转染试剂盒(Polyplus,NA,USA)将线性化的GpBSK-BEV-E0转染至BSR-T7细胞中。

简而言之,将BSR-T7细胞接种到六孔板中,直至覆盖孔底的80%,然后用磷酸盐缓冲盐水(PBS)洗涤。每孔中加入2毫升含2%胎牛血清(FBS;Sigma-Aldrich,St. Louis,MO,USA)的 Dulbecco 改良 Eagle 培养基(DMEM;Life Technologies,CA,USA),并加入 200 μL jetPRIME 缓冲液将 2 μg DNA 添加到灭菌的 1.5 mL 管中并轻轻混合。
随后再加入4 μL jetPRIME,轻轻混匀,低速离心10 s,室温反应10 min。2 . 以 12 小时的间隔观察病毒并收获,直到细胞病变效应 (CPE) 可见。

同时,研究人员还根据标准程序,通过蛋白质印迹检测了拯救的重组病毒rBEV-E0。
简而言之,就是用第10代重组病毒和亲本病毒感染MDBK细胞,并孵育12小时。将病毒样品加载到 12% 聚丙烯酰胺凝胶上,转移到硝酸纤维素膜上,然后用Tris缓冲盐水中的5%脱脂奶和Tween20在37 °C下封闭2小时。
接着将膜与抗BJ101-VP1单克隆抗体(mAb)4B2和抗BVDV E0多克隆抗体(PcAb,1:3000;均在研究人员实验室制备)在37°C下孵育1小时,然后与辣根过氧化物酶一起孵育(HRP)缀合的山羊抗小鼠抗体(1:4000;Sigma-Aldrich)。使用增强化学发光试剂盒进行检测。
结束以上步骤之后,再将24只BALB/c雌性小鼠随机分为 4 组,每组 6 只小鼠,试验组腹腔注射10 8 TCID 50的rBEV-E0,阳性对照组分别免疫相同剂量的BVDV和BEV。
最后一组是用PBS免疫的空白对照组。每天观察小鼠的活动情况,免疫前(D0)和免疫后每隔7天采集血样。

将血样分离成血清,采用间接酶联免疫法(ELISA)检测免疫小鼠体内抗BEV VP1和抗BVDV E0抗体。96 孔 ELISA 板以各 100 ng/mL 的 VP1 和 E0 蛋白包被,并在 4 °C 下孵育过夜。
将孔用含有1%牛血清白蛋白的PBS和Tween在37°C下封闭2小时。添加以1:500 稀释度开始连续稀释两倍的血清样品,并在 37°C 下孵育 1 小时,然后添加 HRP 标记的山羊抗小鼠二抗。
最后加入3,3',5,5'-四甲基联苯胺(TMB)显色,加入2mol/LH 2 SO 4终止反应。450 nm 处的光密度 (OD 450) 确定截止值以进行分析。

由此可见,肠道病毒是一种可引起不同程度疾病的病原体,目前反向基因技术被广泛用于研究肠道病毒的结构和蛋白质功能,以开发病毒载体疫苗。
病毒载体通常用于将遗传物质传递到细胞中,然而,选择合适的病毒载体长期以来一直是基因治疗和载体疫苗开发的主要制约因素。另一个挑战是使用化学灭活疫苗难以有效刺激粘膜免疫。
但BEV这种肠道病原体通常通过肠道或呼吸道感染动物,是克服这一问题的理想选择。BEV在动物中广泛分布,仅导致轻微或无临床症状。此外,BEV具有溶瘤特性,可用作药物治疗。因此,BEV是开发表达外源抗原的活病毒载体的良好候选者。

在前期研究中,研究人员获得了BJ101株的感染性克隆,并成功解救了该病毒。通过比对试验表明,获救病毒rBEV在寄主性、噬菌斑形态、生物学特性和遗传稳定性等方面与亲本株具有相似性。
先前的研究探索了BEV载体中外源基因的各种潜在插入位点,包括2A、2C、3A 和 VP1基因内以及VP1 BC或DE环中VP1和2A基因的连接处。

通过早期研究表明,在这些位点插入外源表位后,不会对病毒生物学或复制产生不利影响。
而在本研究中,研究人员利用反向遗传学平台探讨了使用BEV作为病毒载体表达BVDV E0基因的可行性,并找到了一个新的合适插入位点(2C/3A)。2C蛋白在肠道病毒中高度保守,具有ATP酶活性,可以与RNA和膜结合,与病毒的毒力有关。

从3A 蛋白衍生自 3AB 前体蛋白,并被发现为异构二聚体。在病毒感染过程中,3A蛋白阻止宿主蛋白的形成以及与膜的连接,3A C端疏水区的缺失和突变会影响病毒的复制。
2C/3A 连接处的蛋白水解位点 (ALPQG) 在肠道病毒中高度保守,并被 3C pro识别。因此,本研究在针对插入的BVDV E0基因两侧,设计的引物的基础上引入了ALPQG,使得外源基因插入后2C和3A之间的原始切割位点不会受到影响。

此外,生殖动力学和形态学分析表明,与亲本病毒相比,外源基因对重组病毒的复制和形态没有影响。更重要的是,插入的BVDV E0基因在体外病毒传代过程中传代10次后仍保持稳定,这表明2C/3A连接处可能是外源基因、抗原肽或标记物的理想插入位点。
而除了E0蛋白之外,研究人员还尝试在2C/3A连接处插入HA标签,这也拯救了重组标记病毒(数据未显示)。研究人员还发现可以使用2A(LTTLG)的识别位点来拯救重组病毒(数据未显示),pro不会影响2C/3A蛋白结构的完整性或外源基因的表达。

据报道,牛群中抗 BEV-E 抗体的流行率通常低于抗 BEV-F 抗体的流行率。因此,BJ101作为EV-E病毒,可能比EV-F更适合作为活病毒疫苗载体。
此外,本研究中使用的 BEV BJ101 菌株已被证实是安全的,据研究人员所知,尚未有发病机制的报告。然而,使用 BEV 作为活病毒载体有两个局限性。首先,预先存在的高水平 BEV 抗体可能会阻止疫苗载体引发强烈的免疫反应。

在这项研究中,小鼠仅被感染,但没有表现出任何不良临床症状。研究人员在接种病毒的 BALB/c 小鼠中检测到抗 BVDV E0 和抗 BEV VP1 抗体。接种亲本病毒的小鼠仅产生针对 BEV VP1 的抗体,而接种重组病毒 rBEV-E0 的小鼠产生针对 VP1 和 E0 的高滴度抗体。
其次,与其他小核糖核酸病毒一样,病毒颗粒的空间有限,但足够小以容纳外源序列。在之前的研究中,探索了仅插入几个或几十个氨基酸(例如外源表位和外源标记)的可能性,而本研究插入的BVDV E0基因全长达到227个氨基酸,远远超过了之前插入的序列长度。
这种将最大程度的病毒保护密码插入BEV病毒载体的尝试可以最大限度地提高免疫原性,并提供更全面的疾病保护。

研究人员通过成功构建并拯救了重组病毒rBEV-E0,并证明在2C/3A蛋白连接处插入外源基因BVDV E0不会影响重组病毒的生物学特性,并在体内诱导有效的免疫反应。
这种重组病毒可以为同时预防和控制 BEV 和 BVDV 以及为进一步研究寻找其他外源基因或标记的合适插入位点提供有用的工具。
因此,rBEV-E0为后续外源基因的插入、作用机制的研究以及病毒载体疫苗的进一步开发提供了理想的技术平台。
